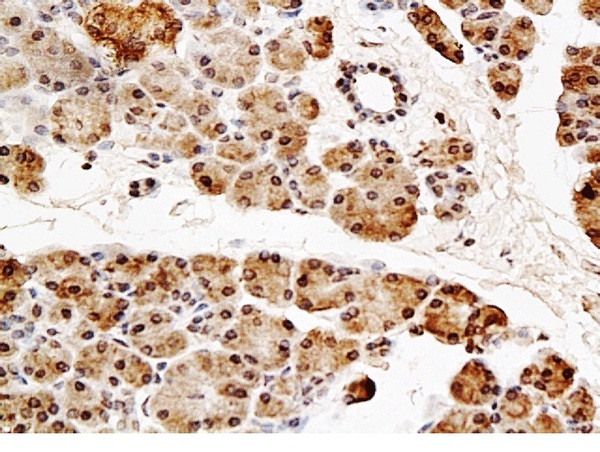
NT5C2 Antibody in Immunohistochemistry (Paraffin) (IHC (P))

Search
Bioss
NT5C2 Polyclonal Antibody
{{$productOrderCtrl.translations['antibody.pdp.commerceCard.promotion.promotions']}}
{{$productOrderCtrl.translations['antibody.pdp.commerceCard.promotion.viewpromo']}}
{{$productOrderCtrl.translations['antibody.pdp.commerceCard.promotion.promocode']}}: {{promo.promoCode}} {{promo.promoTitle}} {{promo.promoDescription}}. {{$productOrderCtrl.translations['antibody.pdp.commerceCard.promotion.learnmore']}}
产品信息
BS-0372R
种属反应
宿主/亚型
分类
类型
抗原
偶联物
形式
浓度
规格
纯化类型
保存液
内含物
保存条件
运输条件
靶标信息
Purine 5-prime-nucleotidase (EC 3.1.3.5) preferentially hydrolyzes inosine 5-prime-monophosphate (IMP) and other purine nucleotides, and is allosterically activated by various compounds, including ATP. The enzyme is exclusively located in the cytoplasmic matrix of cells and may have a critical role in the maintenance of a constant composition of intracellular purine/pyrimidine nucleotides in cooperation with other nucleotidases.
仅用于科研。不用于诊断过程。未经明确授权不得转售。
篇参考文献 (0)
生物信息学
蛋白别名: 5'-nucleotidase (purine), cytosolic type B; 5'-nucleotidase, cytosolic II; cN-II; Cytosolic 5'-nucleotidase II; Cytosolic IMP/GMP-specific 5'-nucleotidase; Cytosolic nucleoside phosphotransferase 5'N; Cytosolic purine 5'-nucleotidase; epididymis secretory sperm binding protein; High Km 5'-nucleotidase; IMP-specific 5'-NT; RP11-30H12.3; spastic paraplegia 45 (autosomal recessive); unnamed protein product
基因别名: 2010002I23Rik; cN-II; CnII; ENSMUSG00000025039; Gm9751; GMP; NT5B; NT5C2; NT5CP; PNT5; SPG45; SPG65
UniProt ID: (Human) P49902, (Mouse) Q3V1L4, (Rat) D3ZMY7
Entrez Gene ID: (Human) 22978, (Mouse) 76952, (Rat) 100363253